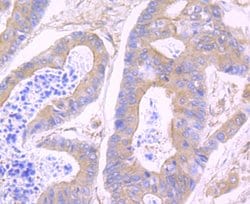
Invitrogen N-WASP Recombinant Rabbit Monoclonal Antibody (JU07-31) 100 &mu;L | Buy Online | Invitrogen&trade; | Fisher Scientific

missing translation for 'onlineSavingsMsg'
Learn More
Learn More
Invitrogen™ N-WASP Recombinant Rabbit Monoclonal Antibody (JU07-31)

Tienda Thermo Scientific Productos

Descripción
N-WASP Recombinant Monoclonal Antibody for Flow, ICC/IF, IHC (P), Western Blot
The Wiskott-Aldrich syndrome (WAS) family of proteins share similar domain structure, and are involved in transduction of signals from receptors on the cell surface to the actin cytoskeleton. The presence of a number of different motifs suggests that they are regulated by a number of different stimuli, and interact with multiple proteins. Recent studies have demonstrated that these proteins, directly or indirectly, associate with the small GTPase, Cdc42, known to regulate formation of actin filaments, and the cytoskeletal organizing complex, Arp2/3. The WASL gene product is a homolog of WAS protein, however, unlike the latter, it is ubiquitously expressed and shows highest expression in neural tissues. It has been shown to bind Cdc42 directly, and induce formation of long actin microspikes.

Especificaciones
Especificaciones
| Antígeno | N-WASP |
| Aplicaciones | Flow Cytometry, Immunohistochemistry (Paraffin), Western Blot, Immunocytochemistry |
| Clasificación | Recombinant Monoclonal |
| Clon | JU07-31 |
| Concentración | 1 mg/mL |
| Conjugado | Unconjugated |
| Formulación | TBS with 0.05% BSA, 40% glycerol and 0.05% sodium azide; pH 7.4 |
| génica | WASL |
| N.º de referencia del gen | O00401, Q91YD9 |
| Alias de gen | 2900021I12Rik; 3110031I02Rik; DKFZp779G0847; MGC48327; n wasp; neural Wiskott-Aldrich syndrome protein; NWASP; N-WASP; TRS4; WASL; WASP like actin nucleation promoting factor; WASPB; Wiskott-Aldrich syndrome like; Wiskott-Aldrich syndrome-like; Wiskott-Aldrich syndrome-like (human) |
| Mostrar más |
Título del producto
Al hacer clic en Enviar, acepta que Fisher Scientific se ponga en contacto con usted en relación con los comentarios que ha proporcionado en este formulario. No compartiremos su información para ningún otro fin. Toda la información de contacto proporcionada se mantendrá de acuerdo con nuestra Política de Privacidad. Política de privacidad.
¿Detecta una oportunidad de mejora?